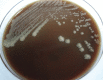

Prototheca wickerhamii cutaneous and systemic infections
- PMID: 25274832
- PMCID: PMC4183384
- DOI: 10.4269/ajtmh.14-0082
Prototheca wickerhamii cutaneous and systemic infections
Abstract
Prototheca wickerhamii, an environmental alga, rarely causes human infections. We present a case of Prototheca wickerhamii cutaneous and systemic infections in an 85-year-old male with adrenal insufficiency. This organism was identified by morphological features and microbiological tests. The patient was successfully treated with ketoconazole.
© The American Society of Tropical Medicine and Hygiene.
Figures

References
Publication types
MeSH terms
Substances
LinkOut - more resources
Full Text Sources
Other Literature Sources

